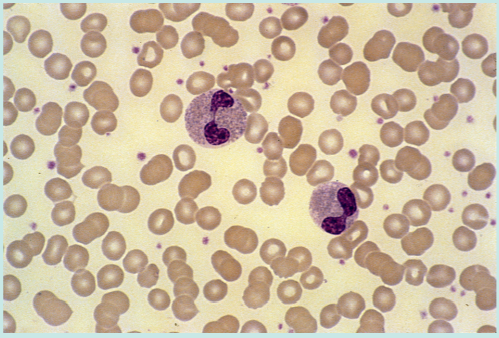

插播一条广告,本实验室有基础医学(免疫学)研究生招生名额少量(可接受推免),主要研究方向为借助单细胞分析技术探索肿瘤微环境中导致免疫逃逸的因素以及通过实验验证,有兴趣的可以联系我。
导 读
免疫系统能够消灭各种各样的病原体。Table21.1描述了补体和吞噬细胞消灭细胞外病原体的过程。免疫系统可利用上图所示的机制,通过肥大细胞和自然杀伤(NK)细胞消灭寄生虫和病毒这两种特殊类型的病原体。本章更加详细地描述了细胞凋亡这一免疫系统通用的杀伤机制。

Table22.1 不同的病原体可激活不同的免疫受体
寄生虫
寄生虫是人类进化过程的一个重要威胁。由于卫生条件的改善,对于发达国家的人们来说这不再是一个严重的问题,但世界上仍有三分之一的人口面临寄生虫问题的威胁。寄生虫有各种各样的形状和大小(从1毫米到10m),并且生命周期比较复杂,包括卵,幼虫和成虫三个阶段。虫卵能抵御胃中的低pH值以及蛋白质的分解消化,直到到达下肠道它们才会孵化。下部肠道为成虫提供了保护,使其免受许多免疫反应成分的影响。为克服这个问题,肥大细胞和嗜酸性粒细胞已经进化为能够对生活在肠道中的蠕虫产生反应(Fig 22.1)。这些细胞被激活后可将有毒物质排放至肠腔中,增加粘液分泌,引起平滑肌收缩,从而驱除蠕虫。Fig22.2总结了这些反应。呼吸道中也进化出了相同的机制。

Fig22.1 免疫系统的杀伤目标

Fig22.2 免疫系统对肠道寄生虫的应答
IgE,免疫球蛋白E;TH,T辅助细胞
肥大细胞
肥大细胞来源于骨髓中一种未知的前体细胞,受辅助性T细胞2(TH2)所分泌的细胞因子如白细胞介素(IL)-3和IL-4的影响。像巨噬细胞一样,肥大细胞存在于一系列正常组织,包括粘膜下层,皮肤和结缔组织(Fig 22.3)。寄生虫感染期间这些组织中募集的肥大细胞数量会显著增加,肥大细胞会在组织中停留数周,这段时间内它们会产生包含多种介质的颗粒。肥大细胞特殊的Fc受体(FcεRI)能与免疫球蛋白E(IgE)结合,该受体对IgE的亲和力非常高,即使人体其他部位产生的IgE水平很低,也能与肥大细胞结合。
因此,肥大细胞可以结合一系列针对多种不同抗原的IgE分子(Table 22.1)。当这些表面IgE分子与抗原交联时,肥大细胞就会被激活(Fig 22.4)。肥大细胞的FcεRIs不同于其他类型的Fc受体,它们结合没有与抗原结合的Ig,并且直到它们被抗原交联才会被激活。肥大细胞也能被过敏毒素C3a和C5a(第20章)和一些药物激活。肥大细胞激活会导致脱颗粒作用,释放之前形成的物质,以及激活花生四烯酸代谢以产生一系列新合成的介质(Table 22.2)。

Fig22.3 肥大细胞。肥大细胞中的颗粒含有细胞因子、组胺和蛋白水解酶。FcεRI,Fc受体;Ig,免疫球蛋白。

Table22.2 肥大细胞介质

Fig22.4 肥大细胞的激活
颗粒中包含的物质
肥大细胞酶
肥大细胞颗粒含有许多蛋白水解酶,包括类胰蛋白酶和胰凝乳蛋白酶。这些酶可增加支气管中的粘液分泌和平滑肌收缩。此外,它们还可裂解和激活补体以及激肽途径的组成部分,从而促进炎症。血中肥大细胞类胰蛋白酶水平可用于严重过敏反应的诊断(Box22.1)。
组胺
组胺可通过引起肠道和肺部平滑肌收缩来驱除寄生虫,并且能通过引起内皮细胞收缩而增加血管通透性,扩大细胞间隙,之后导致组织水肿。组胺还能够提供趋化信号将更多的白细胞吸引到寄生虫感染部位,还会引起皮肤明显的瘙痒,引起感染的宿主对皮肤寄生虫的注意。
细胞因子
像活化的巨噬细胞一样,肥大细胞能够产生一系列的细胞因子来促进和延长炎症反应。肿瘤坏死因子(TNF)是预先形成并存在于颗粒中的,它可激活局部内皮细胞,促进更多炎症细胞的渗出。肥大细胞在受到刺激后还可产生其他细胞因子,与巨噬细胞产生的细胞因子不同,这些细胞因子能够刺激TH2反应。如IL-4可激活TH2细胞,IL-3和IL-5可刺激嗜酸性粒细胞的产生和激活。IL-4和IL-5也会使适应性免疫反应偏离TH1反应。
花生四烯酸代谢产物
花生四烯酸代谢产物由肥大细胞和吞噬细胞产生并通过肥大细胞与抗原结合激活,一般遵循两种不同的途径(Fig22.5):
1.环氧合酶途径产生前列腺素。它们可在几秒钟内起作用,刺激血管扩张,增加血管通透性,并收缩肠和支气管的平滑肌。前列腺素还有其他较慢的作用,例如抑制TH1细胞。
2.脂氧合酶途径产生白三烯。与前列腺素相比,白三烯的作用要慢得多,但有助于支气管和肠道平滑肌的收缩。另外,白三烯对中性粒细胞和嗜酸性粒细胞起趋化刺激作用,因此有助于增加即时反应的细胞密度,并将其转化为延迟或慢性反应。
肥大细胞存在于许多寄生虫感染的组织中。尽管肥大细胞的激活依赖于预先形成的IgE抗体,但它们对抗原刺激的反应非常迅速。组胺、蛋白水解酶和前列腺素引起即时反应,包括平滑肌收缩、血管通透性增加和粘液分泌。细胞因子和白三烯促进对抗原的晚期反应,期间嗜酸性粒细胞和TH2细胞大量涌入。这种晚期炎症可能会转为慢性炎症,但与肉芽肿不同,肉芽肿的特征是巨噬细胞和TH1细胞的存在。

Fig22.5 花生四烯酸代谢
嗜酸性粒细胞
嗜酸性粒细胞与肥大细胞大体相似。但是,有两个因素使它们独一无二:1)某些炎症过程中它们被特异性地募集到组织中 ;2)它们的颗粒含有毒性物质
嗜酸性粒细胞来源于类似于中性粒细胞的前体,并且受到IL-3和IL-5的刺激。血液中的嗜酸性粒细胞较少,但是它们的数量会随着TH2细胞和肥大细胞分泌的IL-3和IL-5的增加而急剧增加。Box22.2讨论了血液中嗜酸性粒细胞数量增加的原因,其被称为嗜酸性粒细胞增多症。嗜酸性粒细胞趋化因子将嗜酸性粒细胞募集到寄生虫感染的部位,这种趋化因子是由上皮细胞和肥大细胞产生的白三烯产生的。
嗜酸性粒细胞能被细胞因子,趋化因子激活,还能被FcεRI上的交联IgE激活。活化的嗜酸性粒细胞除释放出与肥大细胞相同的介质(除组胺外),还释放三种特殊介质:
1.过氧化物酶,释放到寄生虫的表面,然后生成次氯酸
2.主要碱性蛋白质,会破坏寄生虫的外表面和宿主组织
3.阳离子蛋白,它会破坏寄生虫的外表面并充当神经毒素,破坏寄生虫的简单神经系统
速发型(I型)超敏反应
因为嗜酸性粒细胞和肥大细胞脱颗粒的影响非常快,所以这种类型的反应有时被称为速发型超敏反应,尽管释放的细胞因子和其他介质也可以引起迟发性和慢性炎症反应。
生活在发达国家的人们不再受到寄生虫的威胁。在这些人群中,肥大细胞和嗜酸性粒细胞会因一些无害的抗原(如花粉)产生Ⅰ型超敏反应(第27章)。嗜酸性粒细胞和肥大细胞分泌多种介质,其中许多是变态反应治疗的靶标。
自然杀伤(NK)细胞
NK细胞具有两个重要作用。它们是杀死某些被病毒感染的细胞的绝佳杀手,但像巨噬细胞一样,它们还具有刺激适应性免疫反应的作用。在这里,“自然”一词是指这些细胞能够识别靶标并与靶标相互作用,而无需任何激活或先前的敏化作用。
NK细胞是先天免疫系统的一部分,同时也填补了特定免疫反应中的潜在空白。当细胞毒性T淋巴细胞(CTL)识别与主要组织相容性复合体(MHC)结合的病毒肽时,大多数感染病毒(如流感)的细胞在细胞毒作用下被杀死。一些感染性因子,特别是疱疹病毒家族成员,可下调感染细胞上的MHC表达,从而逃避T细胞的检测。疱疹病毒还可以阻断细胞内的抗原提呈途径(第10章)。这些逃逸机制阻止了CTL的识别,但是NK细胞仍然能够识别并杀死感染疱疹病毒的细胞,因为它们已经进化成能够识别并杀死MHC表达低的细胞(Fig22.6)。类似地,一些肿瘤细胞获得了MHC表达降低的突变,它们能够逃避肿瘤特异性T细胞的杀伤,但不能逃避NK细胞的杀伤。

Fig22.6 流感病毒和单纯疱疹病毒感染细胞杀灭作用的比较
NK细胞在骨髓中发育并获得受体。尽管它们不是在胸腺中产生的,但它们与T细胞具有某些共同特征。例如它们与T细胞有一些相同的表面分子,如CD2;并且具有与淋巴细胞相似的外观,因此NK细胞的另一个名称是大颗粒淋巴细胞(Fig22.7)。NK细胞也使用与CTL相同的通用杀伤机制。但是,它们没有重排的T细胞受体分子,因此被归为先天免疫系统。NK细胞还具有巨噬细胞的某些特征:比如能够识别抗体包被的靶细胞,但不能通过吞噬作用杀死它们。

Fig22.7 自然杀伤细胞中的颗粒含有穿孔素和颗粒酶
尽管尚不清楚NK细胞的产生是如何受到调节的,但可以确定的是NK细胞与T和B细胞都是起源于淋巴样祖细胞。NK细胞约占外周血淋巴细胞的5%至15%。它们被细胞因子激活(Fig2.8),但是其杀伤力是通过特殊受体的信号传导来调节的。

Fig22.8 自然杀伤(NK)细胞的细胞因子调控
自然杀伤受体
自然杀伤细胞表达20多种不同的受体,它们属于两个不同的家族,即抑制性受体和激活性受体。
自然杀伤细胞抑制性受体
杀伤性免疫球蛋白样受体(KIR)是免疫球蛋白超家族的成员,可识别特定的MHCα链。NKG2和CD94是识别非经典人类白细胞抗原E(HLA-E)分子的C-凝集素分子。两种类型的受体都是特殊的,因为它们可以抑制杀伤。该主导信号优先于所有其他信号:即如果NK细胞检测到MHC就不会进行杀伤。
自然杀伤细胞激活性受体
NK细胞也表达一些激活性受体。在NK细胞中,一种特殊的Fc受体,FcγRIII,可识别感染细胞表面的与Ig G结合的病毒抗原,并触发杀伤。IgG介导的NK杀伤被称为抗体依赖的细胞介导的细胞毒作用(ADCC),如Fig22.9所示。一些巨噬细胞也表达FcγRIII,在这种情况下,免疫球蛋白IgG起调理作用,触发吞噬作用。

Fig22.9 抗体依赖的细胞介导的细胞毒作用(ADCC)
当NK细胞遇到病毒感染的细胞时,有两种可能的结果(Fig22.10):
1.NK细胞利用先天免疫系统模式识别分子识别细胞是否被感染。NK细胞利用其受体检查细胞表面是否存在MHC。如果MHC处于足够的水平,受体就会发出负信号,阻止NK细胞的杀伤。因为病毒感染的细胞表达MHC,不管怎样它都会被CTL杀死。
2.如果NK识别到一个细胞被病毒感染,并确认MHC水平降低,它就会继续杀死目标细胞。

Fig22.10 左边的自然杀伤(NK)细胞不会杀死被感染的细胞,因为它仍然表达主要组织相容性复合体(MHC),右边被感染的细胞已经停止表达MHC,将会被杀死
刺激信号和抑制信号之间的平衡决定了NK细胞活化的结果,NK优先杀伤不表达MHC的细胞。细胞可能因为病毒感染或癌细胞突变而缺乏MHC的表达,这两个过程都能使异常细胞逃脱CTL的杀伤。NK细胞通过杀死缺乏MHC表达的细胞来克服免疫反应中的这一潜在缺陷。当干扰素γ(IFN-γ)存在时,这种类型的杀伤尤其重要;细胞因子最大限度地提高了正常细胞的MHC表达,同时也增强了NK细胞的活性。MHC表达减少起危险信号的作用,提醒NK细胞注意感染的存在。
NK细胞在胎盘中扮演着更重要的角色,在胎盘中,父亲和母亲的MHC基因都可能表达。NK细胞是妊娠子宫中免疫系统的主要细胞。子宫NK细胞在妊娠期间具有预防子宫和胎儿病毒感染的作用。它们还有一个额外的优势,即使胎儿组织表达外源(父亲的)HLA分子,也不会攻击它。这是因为NK细胞受到MHC的抑制,不管它来自母系还是父系。CTL也能够杀死病毒感染的细胞,但前提是母体MHC上有抗原。相反,CTL会在同种异体反应中攻击表达父系MHC的胎盘细胞,类似于移植反应。
CTL与自然杀伤细胞效应机制
NK细胞使用的细胞毒机制与CTL使用的相同。这两种细胞都通过穿孔素/颗粒酶、Fas配体(FasL)、或分泌TNF诱导细胞程序性死亡(凋亡)。NK细胞和CTL还可分泌免疫调节细胞因子,如干扰素-γ,它能促进Th1炎症反应,激活适应性免疫系统。
穿孔蛋白(穿孔素)
穿孔素存在于NK细胞和CTL的细胞毒颗粒中。当CTL或NK细胞被激活时,肌动蛋白细胞骨架被重组,因此穿孔素分子被移动到细胞表面。穿孔素聚合并形成一个孔,插入到靶细胞膜中,很像补体膜攻击复合体(MAC;见Fig22.9)。这些孔隙允许盐和水流入目标细胞;更重要的是,它们使颗粒酶能够进入细胞质。
颗粒酶
颗粒酶由三种不同的蛋白水解酶组成,通过激活的细胞骨架运输转移至靶细胞。除了降解宿主细胞蛋白外,它们还能特异性地激活caspase酶系统,从而导致细胞凋亡。
Fas配体
Fas配体(FasL)是一种强有力的细胞凋亡诱导剂,NK细胞和CTL通过它来杀伤感染细胞和肿瘤细胞。Fas与TNF受体属于同一受体家族(Fig22.11),Fas和FasL在激活过程中在免疫系统的细胞上表达。当CTL和NK细胞被激活时,FasL的表达增加;FasL与靶细胞上的Fas结合,然后通过后面描述的机制发生凋亡。T细胞也可能表达Fas,并可成为Fas介导的杀伤靶点。例如,免疫特殊部位(如睾丸)的细胞表达FasL。任何意外进入睾丸的T细胞都会暴露在Fas中并发生凋亡。

Fig22.11 Fas和肿瘤坏死因子(TNF)受体均可诱导细胞死亡
NK细胞不仅具有很强的杀伤能力,而且它们也能通过分泌刺激TH1反应的细胞因子来激活适应性免疫反应。巨噬细胞同样如此,这正是我们对先天免疫系统细胞的期望。这两种类型的细胞都识别病原体家族,而不是特定的抗原,他们试图根除病原体,但也会激活适应性免疫系统。
当NK细胞与靶细胞相遇时,它们会分泌干扰素-γ。这种细胞因子刺激TH1细胞,抑制TH2细胞。TH1反应在处理细胞内感染方面特别有效,可以形成免疫记忆,以保证宿主再次暴露于相同病原体时产生强烈反应。
细胞凋亡的细胞内机制
本章主要关注通过连接Fas或TNF受体等诱导的细胞凋亡(见Fig22.11)。然而,无论有多少不同的触发因素,细胞凋亡的细胞内机制是相似的。
Fas和TNF受体都有细胞质尾巴,称为死亡结构域,可以激活caspase系列酶(Fig22.12)。半胱氨酸天冬氨酸蛋白酶(Caspases)是一类蛋白水解酶,它能在天冬氨酸残基后裂解蛋白。激活caspase的最终结果是激活一种特定的DNA酶,它将靶细胞的DNA裂解成200个碱基对长度的片段。当NK或CTL将颗粒酶注入细胞内时,caspase酶也被激活。

Fig22.12 这种B细胞是否发生凋亡取决于Fas、caspases、白细胞介素2(IL-2)和Bcl-2信号之间的平衡
另一个细胞凋亡的早期影响是线粒体的损伤,这会导致线粒体内容物的释放;随后进一步激活半胱氨酸天冬氨酸蛋白酶。Bcl-2是一种抗凋亡蛋白,它结合并稳定线粒体,防止凋亡上调(第17章)。IL-2水平下降会降低Bcl-2在细胞内的浓度,使细胞更容易发生凋亡。这发生在免疫应答成功清除抗原时,抗原水平下降,IL-2分泌减少。
免疫系统中的细胞凋亡
细胞凋亡是细胞程序性死亡的过程,这是一种生理性死亡。凋亡细胞可被吞噬细胞识别,吞噬细胞通常在不激发炎症的情况下清除细胞残留物。相比之下,坏死是细胞的意外死亡,通常是由于新陈代谢出现问题,如缺氧或毒素引起。坏死不会导致DNA片段化,因为它激活补体级联反应,所以通常会导致炎症反应(Table22.3)。

Table 22.3 细胞凋亡与坏死的比较
细胞凋亡是影响许多机体系统的重要生理过程。例如,在胚胎发育期间,细胞凋亡参与组织重塑,如发育中的血管系统。通过这种方式,细胞凋亡决定了发育中的胎儿的形状。
细胞凋亡在形成适应性免疫系统中起着非常重要的作用。自身反应性T和B细胞在胸腺和骨髓中生成后不久就会发生凋亡(防止自身免疫病的发生)。此外,在对病原体产生免疫反应后,多余的淋巴细胞也会通过凋亡被清除。其中每一种都使用不同的凋亡触发机制,但结果是形成了免疫反应的特异性(Table22.4)。

Table22.4 免疫系统中的细胞凋亡
细胞凋亡也参与了一些病理过程,例如,有证据表明,HIV感染破坏CD4+T细胞的方式之一是通过诱导凋亡。当凋亡碎片没有被吞噬细胞充分清除时,它可以具有免疫原性,这会导致自身抗体的产生,例如针对DNA的抗体,这可能会导致自身免疫性疾病,如系统性红斑狼疮(SLE)。
凋亡缺陷可能发生在突变或染色体易位导致Bcl-2水平升高的B细胞克隆中,这些突变或染色体易位的细胞可能会受到保护而免于凋亡,并发展为恶性B细胞肿瘤(第35章)。某些疱疹病毒感染也可导致细胞凋亡缺陷。例如,人类疱疹病毒4型(EBV)通过产生一种类似Bcl-2的蛋白来逃避细胞凋亡。这会使被该种病毒感染的B细胞“永生”,也可能导致B细胞恶性肿瘤的发展。
Box22.1 髋关节置换术中存在的严重问题
67岁女性患者计划接受髋关节置换手术,全麻后开始手术。皮肤切开后4min,静脉注射抗生素头孢呋辛以降低术后感染的风险。大约1分钟后,麻醉师注意到她的血压从150/87 mm Hg大幅下降到65/35 mm Hg。起初,麻醉师怀疑血压下降是由于手术部位出血,但外科医生说这不太可能。几秒钟后,病人的呼吸变得非常困难,他的血氧饱和度已经从97%降到了63%。麻醉师怀疑这是头孢呋辛的过敏反应(严重过敏),于是给他注射了肾上腺素。但病人对肾上腺素的反应较弱,最终麻醉师在血压和通气障碍恢复之前注射三剂肾上腺素。手术放弃。1小时和24小时后分别抽取血样检测肥大细胞类胰蛋白酶(MCT)。
病人在几周后接受过敏专科医生的检查时,肥大细胞类胰蛋白酶的结果MCT水平为245µg/L,次日MCT水平已降至8.5µg/L。MCT的参考范围为0至13µg/L。MCT短暂升高,证实是过敏反应。进一步的测试表明病人确实对头孢呋辛过敏(第27章)。几周后再次尝试该操作。给予不同的抗生素,没有问题。
近期升高的MCT可作为过敏反应的诊断试验。当症状有几种可能的原因时,这一点很重要。这里描述的情况中,血压下降可能是由出血引起的,而患者的通气困难可能是由于气管导管的错位造成的。短暂升高的MCT则强烈表明过敏反应是原因所在。
Box22.2 嗜酸性粒细胞增多症
43岁的男子从东南亚的海外援助工作中归来,他参与了污水处理系统的开发。回家后被要求接受体检,检查期间发现嗜酸性粒细胞计数升高(2.5×106mL,正常范围应<0.35×106mL)和肝功能异常(Fig22.14)。
虽然过敏是发达国家嗜酸性粒细胞增多症的最常见原因,但该患者没有哮喘、鼻炎或湿疹等过敏症状或体征。他也没有任何癌症的特征,癌症有时与嗜酸性粒细胞增多症有关,比如淋巴瘤。肝脏活检显示寄生虫卵被肉芽肿包围。诊断为寄生虫感染性血吸虫病,患者接受治疗的效果良好。
曼氏血吸虫是世界一些地区常见的寄生虫。当幼虫从受污染的水源穿透皮肤时,人类就会受到感染。成虫生活在门静脉中,排出卵子,卵子可寄宿在肝脏内。肥大细胞和嗜酸性粒细胞能够利用上述机制杀死血吸虫和它们的卵。明显的嗜酸性粒细胞增多是这些细胞活化的反映。当卵子解体时,它们会释放多肽,这些多肽被TH1细胞处理并识别为常规抗原。未经治疗的血吸虫病会导致肝脏慢性炎症,是肝硬化的原因之一。目前尚不清楚这种损害是由嗜酸性粒细胞对成虫的反应还是TH1细胞对虫卵的反应,还是两者兼而有之。
Fig 22.14 嗜酸性粒细胞。这些细胞的多叶核表明它们与中性粒细胞关系密切(见Fig21.1A)。注意粗大的红色颗粒。
— THE END —
▉ 往期文章目录
基础免疫学系列
肿瘤免疫学系列
生信入门学习笔记系列
基础实验技术系列
Annexin V/PI染色检测细胞凋亡-OncoLab实验室
仪器操作系列
蔡司LSM800激光共聚焦显微镜操作视频-中西医结合基础研究中心
IN Cell Analyzer2200高内涵细胞成像分析系统操作教程-中西医结合基础研究中心
文献分享系列
年度巨献:神刊CA发布最新癌症数据:全球1000万人死于癌症,中国占比超3成
HLA-I分子加工和递呈抗原功能受损是免疫检查点抑制剂耐药的重要原因
作图投稿选刊系列
GraphPad+AI制作可发表级别的柱状图-OncoLab实验室
PubMed中如何按影响因子筛选检索结果并显示影响因子及分区?
如何使用EndNote软件插入参考文献(附6813种杂志参考文献格式文件)
健康养生系列

关注本号~

加入读者交流群~
本篇文章来源于微信公众号:OncoLab






